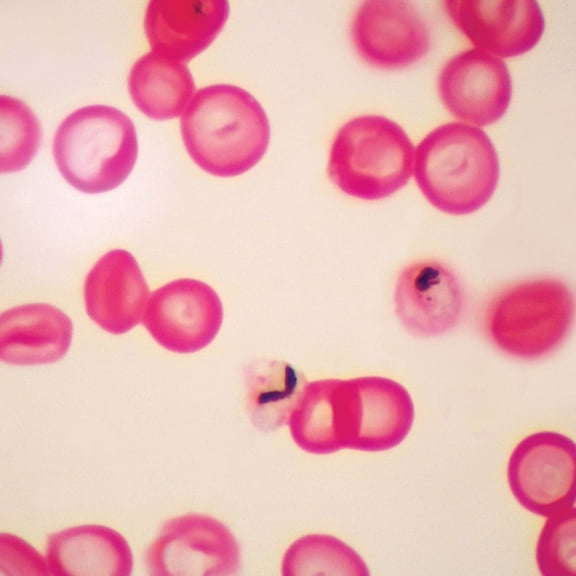
Plasmodium Falciparum Slide, Smear

Hero image 0 of Human Spongy Bone, Sec. 7 M H&E Microscope Slide, 0 of 1
Human Spongy Bone, Sec. 7 M H&E Microscope Slide
(No ratings yet)
Key item features
- Human Spongy Bone, sec
- 7 um H&E - Stained to show general structures.
Specs
Current price is USD$16.50
Price when purchased online
Free 30-day returns
How do you want your item?
Columbus, 43215
Arrives by Fri, Feb 6
|Shipping fee $8.95
Sold and shipped by Carolina Biological Supply Company
4.312925170068027 stars out of 5, based on 147 seller reviews(4.3)147 seller reviews
Free 30-day returns
Similar items you might like
Based on what customers bought
Mammal Bone Marrow Sec. 7 M H&E Microscope Slide $7.60
 $760current price $7.60+$8.95 shipping
$760current price $7.60+$8.95 shippingMammal Bone Marrow Sec. 7 M H&E Microscope Slide
14 out of 5 Stars. 1 reviewsShipping, arrives in 3+ daysHuman Adenocarcinoma Of Breast, Sec. 7 M H&E Microscope Slide $9.75
 $975current price $9.75+$8.95 shipping
$975current price $9.75+$8.95 shippingHuman Adenocarcinoma Of Breast, Sec. 7 M H&E Microscope Slide
Shipping, arrives in 3+ daysZoea Of Crab, W.M. Microscope Slide $8.05
 $805current price $8.05+$8.95 shipping
$805current price $8.05+$8.95 shippingZoea Of Crab, W.M. Microscope Slide
Shipping, arrives in 3+ daysVorticella Slide, W.M. $8.30
 $830current price $8.30+$8.95 shipping
$830current price $8.30+$8.95 shippingVorticella Slide, W.M.
Ascaris Mitosis Slide, Hematoxylin $17.85
 $1785current price $17.85+$8.95 shipping
$1785current price $17.85+$8.95 shippingAscaris Mitosis Slide, Hematoxylin
15 out of 5 Stars. 1 reviewsShipping, arrives in 3+ daysCork Cells, C.S., 12 M Microscope Slide $7.55
 $755current price $7.55+$8.95 shipping
$755current price $7.55+$8.95 shippingCork Cells, C.S., 12 M Microscope Slide
Shipping, arrives in 3+ daysPlasmodium Falciparum Slide, Smear $16.35
$1635current price $16.35+$8.95 shipping
$1635current price $16.35+$8.95 shippingPlasmodium Falciparum Slide, Smear
23 out of 5 Stars. 2 reviewsShipping, arrives in 3+ daysHydra Plain And Budding, W.M. Microscope Slide $10.00
 $1000current price $10.00+$8.95 shipping
$1000current price $10.00+$8.95 shippingHydra Plain And Budding, W.M. Microscope Slide
Shipping, arrives in 3+ daysOral Smear, W.M. Microscope Slide $6.35
 $635current price $6.35+$8.95 shipping
$635current price $6.35+$8.95 shippingOral Smear, W.M. Microscope Slide
Shipping, arrives in 3+ daysParenchyma Tissue, Sec., 12 M Microscope Slide $6.80
 $680current price $6.80+$8.95 shipping
$680current price $6.80+$8.95 shippingParenchyma Tissue, Sec., 12 M Microscope Slide
Butterfly Proboscis, W.M., Microscope Slide $6.75
 $675current price $6.75+$8.95 shipping
$675current price $6.75+$8.95 shippingButterfly Proboscis, W.M., Microscope Slide
Shipping, arrives in 3+ daysStarfish Blastula, W.M. Microscope Slide $9.10
 $910current price $9.10+$8.95 shipping
$910current price $9.10+$8.95 shippingStarfish Blastula, W.M. Microscope Slide
Prokaryotic And Eukaryotic Cells Individual Microscope Slide $10.65
 $1065current price $10.65+$8.95 shipping
$1065current price $10.65+$8.95 shippingProkaryotic And Eukaryotic Cells Individual Microscope Slide
Shipping, arrives in 3+ daysSchistosoma Japonicum Male Slide, W.M. $16.40
 $1640current price $16.40+$8.95 shipping
$1640current price $16.40+$8.95 shippingSchistosoma Japonicum Male Slide, W.M.
Shipping, arrives in 3+ daysHuman Metastatic Carcinoma To Lung, Sec. 7 M H&E Microscope Slide $10.25
 $1025current price $10.25+$8.95 shipping
$1025current price $10.25+$8.95 shippingHuman Metastatic Carcinoma To Lung, Sec. 7 M H&E Microscope Slide
Mixed Protozoa, W.M. Microscope Slide $10.35
 $1035current price $10.35+$8.95 shipping
$1035current price $10.35+$8.95 shippingMixed Protozoa, W.M. Microscope Slide
14 out of 5 Stars. 1 reviewsMammal Spinal Ganglion And Nerve Slide, L.S., 7 M $8.20
 $820current price $8.20+$8.95 shipping
$820current price $8.20+$8.95 shippingMammal Spinal Ganglion And Nerve Slide, L.S., 7 M
Shipping, arrives in 3+ daysCork, Sec., 20 Microscope Slide $5.85
 $585current price $5.85+$8.95 shipping
$585current price $5.85+$8.95 shippingCork, Sec., 20 Microscope Slide
25 out of 5 Stars. 2 reviewsShipping, arrives in 3+ daysMammal Cerebellum, Sec. Microscope Slide, 7 M H&E $7.65
 $765current price $7.65+$8.95 shipping
$765current price $7.65+$8.95 shippingMammal Cerebellum, Sec. Microscope Slide, 7 M H&E
Radiolaria Prepared Microscope Slide, Whole Mount $6.30
 $630current price $6.30+$8.95 shipping
$630current price $6.30+$8.95 shippingRadiolaria Prepared Microscope Slide, Whole Mount
35 out of 5 Stars. 3 reviewsShipping, arrives in 3+ days
About this item
Product details
Human Spongy Bone, sec. 7 um H&E - Stained to show general structures.
- Human Spongy Bone, sec
- 7 um H&E - Stained to show general structures.
info:
We aim to show you accurate product information. Manufacturers, suppliers and others provide what you see here, and we have not verified it.
Specifications
Size
0.03 lbs
Brand
Carolina Biological Supply Company
Warranty
Warranty information
Please be aware that the warranty terms on items offered for sale by third party Marketplace sellers may differ from those displayed in this section (if any). To confirm warranty terms on an item offered for sale by a third party Marketplace seller, please use the 'Contact seller' feature on the third party Marketplace seller's information page and request the item's warranty terms prior to purchase.
Popular items in this category
Best selling items that customers love
Microscope Slides Concave $15.99
 Sponsored$1599current price $15.99
Sponsored$1599current price $15.99Microscope Slides Concave
Shipping, arrives in 3+ daysTrichomonas Vaginalis Slide, Smear $13.90
 $1390current price $13.90+$8.95 shipping
$1390current price $13.90+$8.95 shippingTrichomonas Vaginalis Slide, Smear
23 out of 5 Stars. 2 reviewsShipping, arrives in 3+ daysCover Glasses, Circles, 12 Mm, Thickness 0.13-0.17 Mm $24.55
 $2455current price $24.55+$8.95 shipping
$2455current price $24.55+$8.95 shippingCover Glasses, Circles, 12 Mm, Thickness 0.13-0.17 Mm
75 out of 5 Stars. 7 reviewsShipping, arrives in 3+ daysAmScope PS100D Prepared Microscope Slide Set for Basic Biological Science .. $66.99
 $6699current price $66.99+$9.99 shipping
$6699current price $66.99+$9.99 shippingAmScope PS100D Prepared Microscope Slide Set for Basic Biological Science ..
Shipping, arrives in 3+ daysUKCOCO- 10Pcs Microscop Slides Biology Prepared Slides Animal Microscope Specimens Biological Sample Glass $5.99 Was $8.69
 Now$599current price Now $5.99, Was $8.69$8.69+$3.98 shipping
Now$599current price Now $5.99, Was $8.69$8.69+$3.98 shippingUKCOCO- 10Pcs Microscop Slides Biology Prepared Slides Animal Microscope Specimens Biological Sample Glass
Shipping, arrives in 3+ daysAmScope PS200A Anatomy Pathology Botany Prepared Microscope Slides $122.99
 $12299current price $122.99
$12299current price $122.99AmScope PS200A Anatomy Pathology Botany Prepared Microscope Slides
Shipping, arrives in 3+ days10pk Spongy Bone Section (Mammal), Prepared Microscope Slides - 75 x 25mm - Classroom Pack, 10 Slides in Storage Case - Anatomy, Biology & Microscopy - Eisco Labs $24.09
 $2409current price $24.09
$2409current price $24.0910pk Spongy Bone Section (Mammal), Prepared Microscope Slides - 75 x 25mm - Classroom Pack, 10 Slides in Storage Case - Anatomy, Biology & Microscopy - Eisco Labs
AmScope 50 Biology Pathology Prepared Microscope Slides Set New $30.99
 $3099current price $30.99+$6.99 shipping
$3099current price $30.99+$6.99 shippingAmScope 50 Biology Pathology Prepared Microscope Slides Set New
Shipping, arrives in 3+ daysVegetative Spirogyra, Wholemount - Prepared Microscope Slide - 75 x 25mm - Biology & Microscopy - Eisco Labs $7.99
 $799current price $7.99
$799current price $7.99Vegetative Spirogyra, Wholemount - Prepared Microscope Slide - 75 x 25mm - Biology & Microscopy - Eisco Labs
Shipping, arrives in 3+ days10PK Vegetative Spirogyra, Wholemount - Prepared Microscope Slides - Classroom Pack, 10 Slides in Storage Case - Biology & Microscopy - Eisco Labs $23.09
 $2309current price $23.09
$2309current price $23.0910PK Vegetative Spirogyra, Wholemount - Prepared Microscope Slides - Classroom Pack, 10 Slides in Storage Case - Biology & Microscopy - Eisco Labs
Shipping, arrives in 3+ daysWholemount of Letter 'e', Prepared Microscope Slide - 75 x 25mm - Introductory Microscopy - Eisco Labs $9.99
 $999current price $9.99
$999current price $9.99Wholemount of Letter 'e', Prepared Microscope Slide - 75 x 25mm - Introductory Microscopy - Eisco Labs
Shipping, arrives in 3+ daysTOMLOV Digital Microscope Extension Tube ET02,6 inch Extender Pole for LCD Microscope $29.99
 $2999current price $29.99
$2999current price $29.99TOMLOV Digital Microscope Extension Tube ET02,6 inch Extender Pole for LCD Microscope
Shipping, arrives in 3+ daysAmScope Microscope Slides, 100 Blank Slides with 100 Cover Glass $16.99
 $1699current price $16.99
$1699current price $16.99AmScope Microscope Slides, 100 Blank Slides with 100 Cover Glass
15 out of 5 Stars. 1 reviewsSave withShipping, arrives in 2 days10PK Chloroplasts - Prepared Microscope Slides - Classroom Pack, 10 Slides in Storage Case - Biology & Microscopy - Eisco Labs $19.99
 $1999current price $19.99
$1999current price $19.9910PK Chloroplasts - Prepared Microscope Slides - Classroom Pack, 10 Slides in Storage Case - Biology & Microscopy - Eisco Labs
Shipping, arrives in 3+ daysAmScope Vital Stain Kit for Living Cells – Microscope Slide Stains, Pipettes & 50 Slides New $47.99
 $4799current price $47.99+$9.99 shipping
$4799current price $47.99+$9.99 shippingAmScope Vital Stain Kit for Living Cells – Microscope Slide Stains, Pipettes & 50 Slides New
15 out of 5 Stars. 1 reviewsShipping, arrives in 3+ daysMonocot & Dicot Root, Cross Section - Prepared Microscope Slide - 75 x 25mm - Biology & Microscopy - Eisco Labs $7.99
 $799current price $7.99
$799current price $7.99Monocot & Dicot Root, Cross Section - Prepared Microscope Slide - 75 x 25mm - Biology & Microscopy - Eisco Labs
Shipping, arrives in 3+ days25pc Prepared Glass Microscope Slides in Wood Case with Plant, Fungus, Insect and Mammal Specimens $17.99
 $1799current price $17.99
$1799current price $17.9925pc Prepared Glass Microscope Slides in Wood Case with Plant, Fungus, Insect and Mammal Specimens
194.6 out of 5 Stars. 19 reviewsSave withShipping, arrives in 2 daysAmScope 25 Glass Prepared Zoological and Botanical Microscope Slides with Plastic Box New $16.99
 $1699current price $16.99
$1699current price $16.99AmScope 25 Glass Prepared Zoological and Botanical Microscope Slides with Plastic Box New
12 out of 5 Stars. 1 reviewsSave withShipping, arrives in 2 days
Customer ratings & reviews
0 ratings|0 reviews
This item does not have any reviews yet
